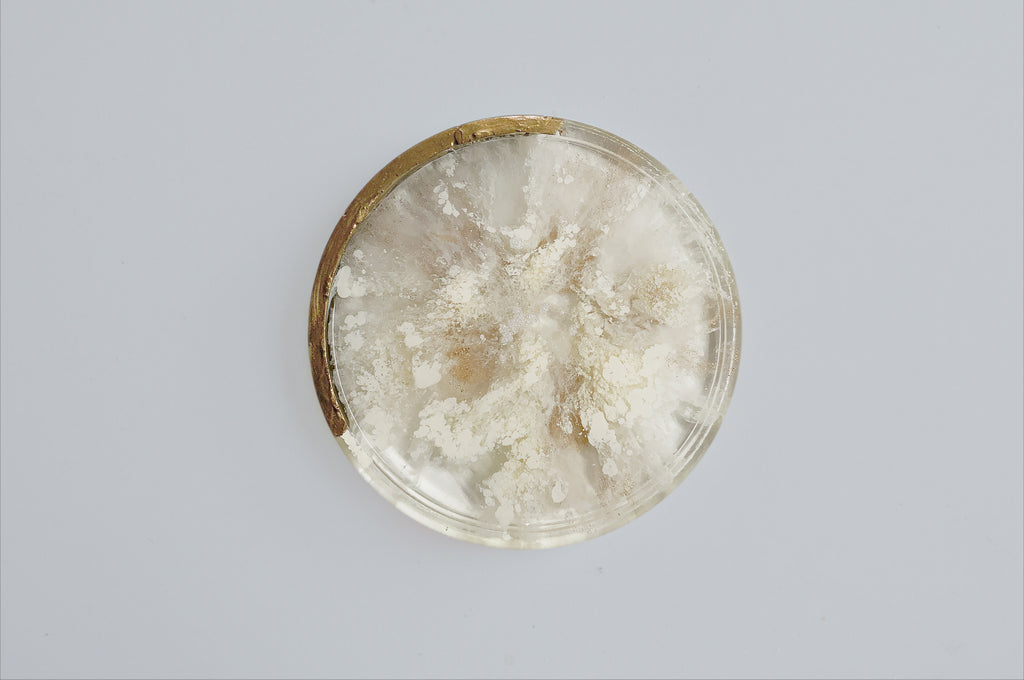
雲紗暮白 樹脂渲染冷水盤 Cloudveil White | Resin rendering cold water coaster

跳到商品資訊


雲紗暮白 樹脂渲染冷水盤 Cloudveil White | Resin rendering cold water coaster
$1,688.00
商品說明 Description
雲紗暮白
輕紗般的雲霧繚繞且單純
宛若靜謐與最溫柔的低語
悠悠的安撫著日常的奔波
彷彿將塵囂隱去留下純粹
釋放心靈在光影間找平衡
放慢腳步將自己交給時間
・
大款規格:10 × 10 × 1 cm
小款規格:08 × 08 × 1 cm
材質:樹脂
用途:冷水杯墊
*渲染作品每個紋路皆不同
-
Cloudveil White
The gauze-like clouds are shrouded in mist and simple.
It is like the quietest and most gentle whisper.
leisurely soothing the daily rush.
It seems to hide the hustle and bustle and leave purity.
Release your mind to find a balance between light and shadow.
Slow down and give yourself over to time.
・
Large size : 10 × 10 × 1 cm
Small size:08 × 08 × 1 cm
Material: Resin Usage: cold water coaster
*Each texture of the rendered work is different
送貨方式 Shipping method
- 7-11 取貨不付款 (C2C)
- 全家 取貨不付款 (C2C)
付款方式 Payment methods
- 綠界科技 - ATM虛擬帳號